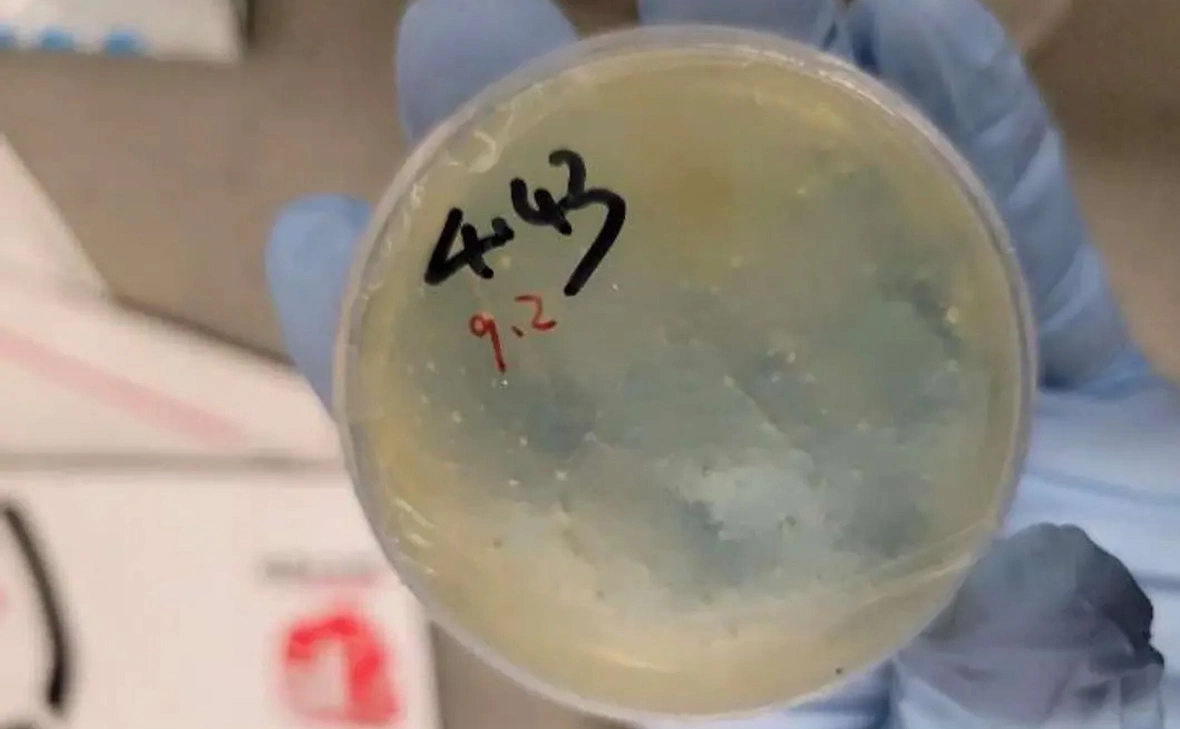
US District Court for the Eastern District of Michigan

В США арестовали китайского ученого за посылки с чашкой Петри из Уханя
В Соединенных Штатах задержали китайского ученого за попытку провезти биоматериалы, «связанные с круглыми червями». До этого там неоднократно обвиняли в контрабанде других ученых, в том числе из Китая и России
Фото: US District Court for the Eastern District of Michigan
В США задержали аспирантку Колледжа естественных наук и технологий при Университете науки и технологий Хуачжун (HUST) в Ухане Чэнсюань Хань за попытку провести в страну чашки Петри с биоматериалом, передает The New York Post.
Пограничники обнаружили, что Хань в 2024 и 2025 году отправила четыре посылки, «содержавшие биологический материал, связанный с круглыми червями». Они предназначались для тех, кто связан с лабораторией Мичиганского университета. Сама аспирантка настаивала, что не отправляла ничего такого и что в коробках были пластиковые стаканчики, а не чашки Петри.
В ФБР заявили, что «контрабанда биологических материалов» представляет «прямую угрозу общественной и национальной безопасности и подрывает целостность исследовательских институтов страны».
Хань стала третьей среди китайских ученых, кого обвинили в контрабанде биологических материалов в Мичиган за последнее время. В частности, в прошлом году были арестованы сотрудница лаборатории Мичиганского университета Юньцин Цзянь и ее парень Цзуньюн Лю при попытке провезти образцы опасного грибка, убивающего урожай.
Сенатор Джони Эрнст тогда сказал, что ФБР, возможно, перехватило «потенциальное биологическое оружие». Однако молекулярный биолог из Ратгерского университета Ричард Эбрайт сообщил, что грибок Fusarium graminearum существует в США уже более 40 лет и его появление в стране само по себе не представляет новой угрозы. По словам ученого, если бы китайцы ввозили грибок, соблюдая все процедуры, то ввоз «почти наверняка был бы одобрен и арестов не произошло бы».
В начале года в США за контрабанду эмбрионов лягушки задержали сотрудницу Гарварда, ученую из России Ксению Петрову. В американском Минюсте заявили, что перевозимые ею биологические материалы не были задекларированы. Сама Петрова утверждала, что не была уверена, нужно ли их декларировать.
В мае ученую перевели из следственного изолятора в Луизиане в федеральную тюрьму. В США ей грозит тюремное заключение сроком до 20 лет.
Читайте РБК в Telegram.









